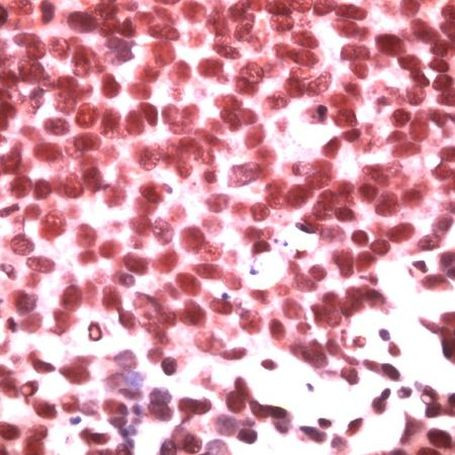
ID3 Antibody in Immunohistochemistry (IHC)

Search
Invitrogen
ID3 Polyclonal Antibody
{{$productOrderCtrl.translations['antibody.pdp.commerceCard.promotion.promotions']}}
{{$productOrderCtrl.translations['antibody.pdp.commerceCard.promotion.viewpromo']}}
{{$productOrderCtrl.translations['antibody.pdp.commerceCard.promotion.promocode']}}: {{promo.promoCode}} {{promo.promoTitle}} {{promo.promoDescription}}. {{$productOrderCtrl.translations['antibody.pdp.commerceCard.promotion.learnmore']}}
产品信息
PA5-32450
宿主/亚型
分类
类型
抗原
偶联物
形式
保存条件
运输条件
RRID
产品详细信息
Heat-mediated antigen retrieval is recommended prior to staining, using a 10mM citrate buffer, pH 6.0, for 10 minutes followed by cooling at room temperature for 20 min. Following antigen retrieval, incubate samples with primary antibody for 30 min at room temperature. A suggested positive control is breast carcinoma.
靶标信息
Members of the Id family of basic helix-loop-helix (bHLH) proteins include ID1, ID2, ID3 and ID4. They are ubiquitously expressed and dimerize with members of the class A and B HLH proteins. Due to the absence of the basic region, the resulting heterodimers cannot bind DNA. The ID-type proteins thus appear to negatively regulate DNA binding of bHLH proteins. Since ID1 inhibits DNA binding of E12 and Myo D, it apparently functions to inhibit muscle-specific gene expression. Under conditions that facilitate muscle cell differentiation, the ID protein levels fall, allowing E12 and/or E47 to form heterodimers with Myo D and myogenin, which in turn activate myogenic differentiation. It has been shown that expression of each of the ID proteins is strongly dependent on growth factor activation and that reduction of ID mRNA levels by antisense oligonucleotides leads to a delayed reentry of arrested cells into the cell cycle following growth factor stimulation.
仅用于科研。不用于诊断过程。未经明确授权不得转售。